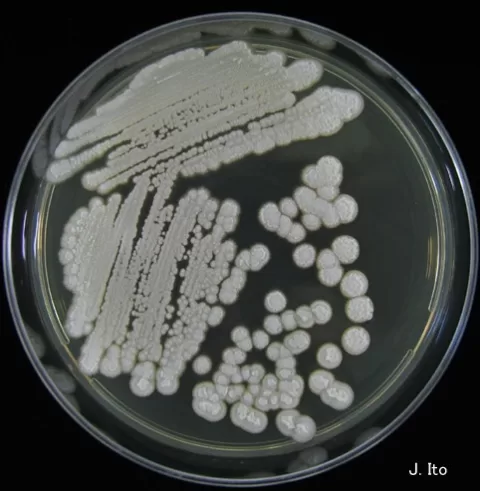

Public health funding cuts have become a pressing concern as a coalition of 23 states has taken legal action against the federal government, challenging the drastic decision to slash $11 billion in support for COVID-19 and vital public health initiatives. These cuts come alongside alarming announcements of personnel reductions and restructuring at the Department of Health and Human Services (HHS), raising fears about the impact on health services. The states argue that not only are these budget reductions illegal, but they also threaten to undermine public health infrastructures, potentially increasing risks for future pandemics and outbreaks. Attorneys general highlight that these funding losses could halt essential programs ranging from disease surveillance to vaccination efforts, with dire consequences for community health. As debates about the implications of funding decisions continue, the case underscores the urgent need to defend public health amidst concerns over the HHS restructuring implications and their fallout on broader health policies.
The recent legal challenge against reductions in public health financing marks a significant shift in how states are responding to federal decisions affecting their health resources. As states grapple with what others deem as health infrastructure cuts, the implications for local health departments are severe, threatening to dismantle long-standing services crucial for community health. Additionally, the backdrop of the COVID funding lawsuit emphasizes a collective urgency among states to advocate for necessary financial support in order to sustain public health efforts. In redefining the conversation around public health funding, the focus shifts to the broader implications of such cuts on public health preparedness and response capabilities. As public agencies like the FDA navigate leadership changes and cope with workforce impacts, the ramifications of these funding decisions will likely echo through health policy discussions for years to come.
The Legal Battle Against Public Health Funding Cuts
In a striking response to the recent public health funding cuts, 23 states have united in a federal lawsuit challenging the $11 billion reduction imposed by the federal government. This lawsuit, filed in Rhode Island, marks a significant legal maneuver by state governments that believe the cuts to funding critical public health initiatives, including responses to COVID-19, are not only unjustified but also illegal. Attorneys general from various states assert that these funding cuts threaten to dismantle public health infrastructure at a time when it is most needed to prevent disease outbreaks and maintain essential services.
The legal documentation reveals that states are contending the rationale behind the cuts lacks substantial evidence. By claiming that COVID-19 is no longer a public health emergency, the federal government has overlooked the need for ongoing funds that support diverse public health initiatives. As states prepare for projected increases in public health threats, this legal battle is about more than just monetary compensation; it is about asserting the rights and responsibilities of state governments to protect public health.
Impact of Health Infrastructure Cuts on State Health Departments
The recent funding cuts have immediate and drastic effects on health departments across the nation. In Minnesota, for example, the Department of Health was forced to notify approximately 300 staff members of layoffs and position cuts due to the loss of over $220 million in federal funding. The consequences of these cuts extend beyond just individual job losses; they compromise the state’s ability to effectively respond to public health crises. Layoffs have affected critical operations such as laboratory testing, disease surveillance, and vaccination efforts, suggesting a concerning regression in public health preparedness.
Experts warn that the sudden reduction in funding has hampered not only current public health initiatives but also the technological advancements necessary for future preparedness. Susan Kansagra, Chief Medical Officer for the Association of State and Territorial Health Officials, highlights the dangerous situation where health departments attempted to adapt quickly but faced significant limitations due to the loss of funding. The reduced workforce and resources inevitably lead to a decreased capacity for managing emerging health threats, raising serious concerns about the nation’s overall public health infrastructure.
Federal Reorganization and Its Implications for Public Health
The recent restructuring of the Department of Health and Human Services (HHS) has added another layer of complexity to the issue of public health funding cuts. The removal of key personnel, including the FDA’s top vaccine official, has raised alarm about the continuity and leadership within the health sector. Specifically, this transition in leadership can disrupt ongoing initiatives, such as vaccine distribution and public health policy execution, at a time when stability is crucial. State health officials are calling for clarity regarding the impact of these leadership changes on public health funding and operations.
As members of Congress press for testimonies concerning the restructuring at HHS, there is a palpable sense of urgency about understanding how these changes might affect public health delivery systems across states. Lawmakers are particularly concerned that the arbitrary nature of these cuts could hinder HHS’s ability to meet its legislative obligations towards public health. With mounting pressures from both within the Senate and the House, HHS is facing scrutiny over how restructuring strategies align with national health priorities and the well-being of the American public.
The Future of Vaccine Leadership Amidst Funding Cuts
As the FDA appointed Scott Steele as the acting director of the Center for Biologics Evaluation and Research following the exit of Dr. Peter Marks, concerns regarding the future of vaccine leadership have intensified. This change occurs against a backdrop of funding cuts that jeopardize the robust vaccine programs integral to public health strategy. Vaccine leadership must not only navigate the complexities of emerging variants and public perceptions but also grapple with reduced operational support from federal resources.
The timely and effective deployment of vaccines relies heavily on a well-supported public health framework and continuous innovation in response to health threats. Stakeholders in the public health sector express apprehensions that the recent shifts in vaccine leadership, coupled with diminishing funds, could hinder progress in immunization efforts. The upcoming months will be critical as vaccines remain a frontline defense against communicable diseases, necessitating strong and stable leadership to ensure public trust and engagement in vaccination initiatives.
The Role of States in Public Health Litigation
With 23 states now engaged in a lawsuit against the federal government regarding public health funding cuts, the dynamics of state involvement in public health litigation are evolving. States are increasingly recognizing their role not just as recipients of public health funds but as active participants in shaping health policy and funding decisions. This litigation represents a collective effort to ensure that state health departments have the necessary resources to prevent public health crises and manage emerging threats.
The implications of successful litigation could set a precedent for future funding allocations and empower states to assert their needs and responsibilities in public health. As the lawsuit unfolds, it may encourage further collaboration among states to protect their interests against federal budgetary decisions that could jeopardize health infrastructure. By standing united, these states signal a powerful message to the federal government: that public health is a non-negotiable priority that demands attention and adequate funding.
Political Implications of Health Funding Cuts
The political landscape surrounding public health has shifted significantly in light of the recent funding cuts. Lawmakers from both parties are calling for hearings to investigate the rationale behind the cuts and their potential repercussions on public health objectives. This bipartisan concern indicates the widespread recognition that public health is a vital issue transcending political divisions. The implications of these funding cuts will inevitably affect how parties approach health policy, particularly as they relate to pandemic preparedness and health equity.
Moreover, this situation highlights the interconnectedness of public health funding and political accountability. As constituents express their concerns regarding the potential fallout from these cuts, elected officials may find increased pressure to advocate for restored funding and support for public health initiatives. The local ramifications of federal decisions reinforce the notion that public health funding is a pivotal issue that can sway voter sentiment, making it a key talking point in upcoming elections.
Public Health Infrastructure: A Call for Resilience
The recent upheaval in public health funding has ignited a call for resilience in the public health infrastructure across the United States. As states grapple with personnel layoffs and impending service cuts, it is becoming clear that the systems designed to protect the population must be fortified. The need for a resilient framework that can withstand budgetary constraints and sudden policy shifts has never been more urgent, prompting experts to advocate for strategic investments in health infrastructure.
Resilience in public health means ensuring that critical services remain intact and that health departments are equipped to respond dynamically to emerging health emergencies. As the public health community confronts the ongoing challenges presented by funding cuts, there is a consensus on the importance of building systems that prioritize adaptability and sustained investment, irrespective of the political landscape. By embracing resilience, public health officials aim to secure the future of health services vital to community well-being.
Challenges of Technological Advancements in Public Health
One of the often-overlooked impacts of public health funding cuts is the slowdown in technological advancements within health departments. Agencies that focus on modernizing data systems and implementing technological solutions for public health surveillance are facing severe constraints as they adjust to diminished funding. The cuts not only lead to staff reductions but also hinder projects that are critical for the integration of technology in public health responses, which can greatly enhance efficiency and effectiveness.
The lack of investment in technology can create long-term setbacks, especially as new health threats continue to emerge. Public health officials emphasize that the integration of advanced technologies, such as data analytics and telehealth solutions, is essential for effective disease tracking and management. With funding cuts now jeopardizing these advancements, there is a growing call for renewed investment in technological infrastructures that will enable health departments to proactively address public health challenges.
Expectations from Federal Health Agencies Post-Cuts
As state officials and public health advocates respond to the recent funding cuts, there is a heightened expectation for federal health agencies to demonstrate accountability and transparency. The abrupt nature of cuts has led to widespread concern regarding the decision-making processes behind these changes, with many advocating for a clearer articulation of the federal government’s plans to support public health in a reduced funding environment. The calls for hearings and testimony underscore the need for comprehensive communication regarding health agency operations and their capacity to fulfill mandates.
Moreover, stakeholders are urging federal agencies to reassess their strategies and Commitments to public health funding. By engaging state officials and public health experts in meaningful dialogue, federal agencies have a unique opportunity to recalibrate their approaches to health funding. This collaboration could potentially foster trust and assure states that federal agencies are committed to bolstering a resilient public health infrastructure, even in times of fiscal constraint.
Frequently Asked Questions
What are the implications of public health funding cuts on COVID response efforts?
Public health funding cuts significantly undermine the ongoing response to COVID-19. As federal funding is reduced, states face layoffs of critical staff involved in vaccination, disease surveillance, and public health infrastructure. The lawsuit filed by 23 states highlights concerns that these cuts could increase the risks of future pandemics and other health crises, as essential public health services are jeopardized.
How do the COVID funding lawsuit and public health funding cuts affect state health departments?
The COVID funding lawsuit asserts that public health funding cuts will have dire consequences for state health departments. These cuts have already led to significant layoffs, affecting staff working on key health initiatives. State health departments report a halt in technological advancements and lab testing capacities, which are crucial for managing public health threats. The lawsuit emphasizes the need for adequate funding to maintain robust health infrastructure.
What are the consequences of FDA vaccine leadership changes amid public health funding cuts?
The recent changes in FDA vaccine leadership come at a time when public health funding cuts are disrupting vital health services. The appointment of an acting director for CBER amid these cuts raises concerns about the FDA’s ability to effectively manage vaccine development and public health preparedness. This restructuring, combined with funding cuts, could hinder the progress made in vaccination efforts and response to health threats.
What are the arguments presented against public health funding cuts in the states’ lawsuit?
The states’ lawsuit against public health funding cuts argues that the federal government lacks a rational basis for its decision to cut $11 billion in vital funding. The attorneys general contend that these cuts will severely impact public health, jeopardizing pandemic preparedness and essential services at a time when such infrastructure is critically needed. The lawsuit calls for a reassessment of these cuts to ensure that public health remains a priority.
How will restructuring at HHS impact public health services?
Restructuring at HHS amid public health funding cuts raises alarms about the future of public health services. With thousands of layoffs, the capacity to fulfill statutory responsibilities is threatened, risking the ability to respond effectively to health crises. Lawmakers have expressed concerns that such arbitrary cuts could undermine public health agency functions and lead to detrimental outcomes for community health and safety.
| Key Points | Details |
|---|---|
| States sue against funding cuts | 23 states filed a lawsuit against the federal government challenging $11 billion in funding cuts for COVID-19 and other public health projects. |
| Impact of cuts | The cuts could severely impact public health, increasing pandemic risks and eliminating essential services. |
| Minnesota layoffs | Minnesota’s Department of Health announced layoffs of 170 staff and at-risk notices for a total of 300 due to funding cuts. |
| Rationale for cuts | Officials claim the cuts are justified as COVID is no longer a public health emergency, but they actually harm broader public health infrastructure. |
| FDA leadership change | Scott Steele appointed as acting director of the Center for Biologics Evaluation and Research following the removal of Peter Marks. |
| Congressional concerns | Bipartisan lawmakers are calling for hearings to discuss the impact of HHS restructuring and personnel cuts. |
Summary
Public health funding cuts are creating an alarming situation as states stand up against the federal government to fight against a significant reduction of $11 billion. The cuts threaten the backbone of public health responses, risking increased disease outbreaks and undermining critical health services just when they are most needed. With over 170 job losses reported in Minnesota alone and congressional members voicing their concerns, it is evident that the abrupt cuts cannot be taken lightly. The implications for pandemic preparedness and public health infrastructure are dire, making it imperative for the government to reassess these funding reductions.
The content provided on this blog (e.g., symptom descriptions, health tips, or general advice) is for informational purposes only and is not a substitute for professional medical advice, diagnosis, or treatment. Always seek the guidance of your physician or other qualified healthcare provider with any questions you may have regarding a medical condition. Never disregard professional medical advice or delay seeking it because of something you have read on this website. If you believe you may have a medical emergency, call your doctor or emergency services immediately. Reliance on any information provided by this blog is solely at your own risk.